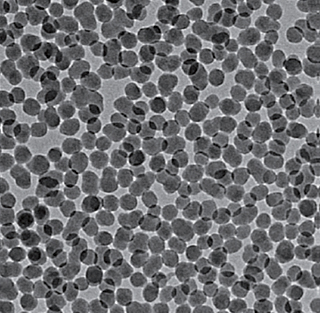

Perfectly Spherical, Fine Particles of Silica: SEAHOSTAR™
- Main Applications
Resin fillers, Anti-blocking agents, Fillers for liquid crystal sealing agents
- Applications
- Functions
Basic Information
SEAHOSTAR™ KE are spherical fine particles of silica with an average particle diameter that is controlled in the 0.1 – 2.5 μm range, and a sharp particle size distribution. Nippon Shokubai offers four types of SEAHOSTAR™ KE: EG (ethylene glycol) dispersion (KE-E), Water dispersion (KE-W), Powder (KE-P), and High purity powder (KE-S). We can also provide KE-S as a surface-treated and various functional groups-imparting type to meet the user’s requirements and preferences.

Features and Properties
- Fine sharp particle and narrow particle size distribution
- Particle size adjustable from 0.1 – 2.5μm
- High purity
- Non-crystalline
- Exist as primary particles with few secondary aggregates
Examples of Applications
- Resin fillers
- Anti-blocking agents
- Fillers for liquid crystal sealing agents
Product Details
SEAHOSTAR™ KE-E Properties
Features
Spherical fine particles of silica are monodispersed in ethylene glycol (EG) to form a milky white, homogenous slurry.
Properties
| Type | Particle Properties | Slurry Properties | |||
|---|---|---|---|---|---|
| Average Particle Diameter (μm) | True Specific Gravity | Refractive Index | Solid Content (%) | Specific Gravity | |
| E10 | 0.1 | 2 | 1.43 | 20 | 1.2 |
| E30 | 0.3 | ||||
| E150 | 1.5 | ||||
SEAHOSTAR™ KE-W Properties
Features
Spherical fine particles of silica are monodispersed in water to form a milky white, homogenous slurry.
Properties
| Type | Particle Properties | Slurry Properties | |||
|---|---|---|---|---|---|
| Average Particle Diameter (μm) | True Specific Gravity | Refractive Index | Solid Content (%) | Specific Gravity | |
| W10 | 0.1 | 2 | 1.43 | 15 | 1.1 |
| W30 | 0.3 | 20 | |||
| W50* | 0.5 | 20 | |||
SEAHOSTAR™ KE-P Properties
Features
Spherical fine particle powder of silica.
* Approximately 10wt% of lower alcohols and other substances derived from the synthetic process are adsorbed on the particle surface.
Properties
| Type | Average Particle Diameter (μm) | True Specific Gravity | Refractive Index |
|---|---|---|---|
| P10 | 0.1 | 1.9 | 1.43 |
| P30 | 0.3 | ||
| P50 | 0.5 | ||
| P100 | 1 | ||
| P150 | 1.5 | ||
| P250 | 2.5 |
SEAHOSTAR™ KE-S Properties
Features
High purity, spherical fine particle powder of silica.
* KE-S is a high-purity product produced by removing organic components on KE-P by high-temperature processing, and is suitable for electronic material applications.
Properties
| Type | Average Particle Diameter (μm) | True Specific Gravity | Refractive Index |
|---|---|---|---|
| S10* | 0.1 | 2.2 | 1.43 |
| S30 | 0.3 | ||
| S50 | 0.5 | ||
| S100 | 1 | ||
| S150 | 1.5 | ||
| S250* | 2.5 |
* Please be sure to read the Chemical Products Safety Data Sheet (SDS) when handling this product.
Newly Developed Technology
Silica Nanoparticle Dispersion Liquid
This dispersion has excellent stability, combined with the features of the SEAHOSTAR™ KE Series.
Excellent dispersibilty in various organic solvents.
Examples: MIBK, PGMEA, PGM, IPA, EG etc.
Incorporation of various kinds of functional groups.
Examples: methacryl, phenyl, methyl etc.
IX-3-NP Series
Dispersion liquid with the ability to arbitrarily control the particle diameter within the 10 – 100 nm range.
Example: IX-3-NP-M-02-H (20 nm)
| Properties | IX-3-NP-M-02-H |
|---|---|
| Dispersion Medium | Methyl isobutyl ketone (MIBK) |
| Surface Treatment (Functional Group) | Methacryl group |
| Average Particle Diameter | 20 nm |
| Particle Size Distribution (CV value) | 6 % |
| Particle Concentration | 30 wt% |
| Specific Surface Area | 230 m²/g |
| True Specific Gravity | 2.1 |
| Metals Content | < 1 ppm |

Examples of Applications
- Additives for optical films
- Fillers for semiconductor sealing materials
- Raw materials for dental materials
* Please be sure to read the Chemical Products Safety Data Sheet (SDS) when handling this product.
Nippon Shokubai’s Fine Particles
